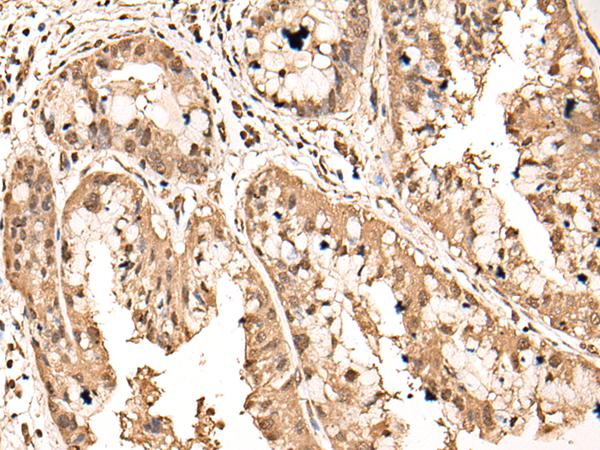
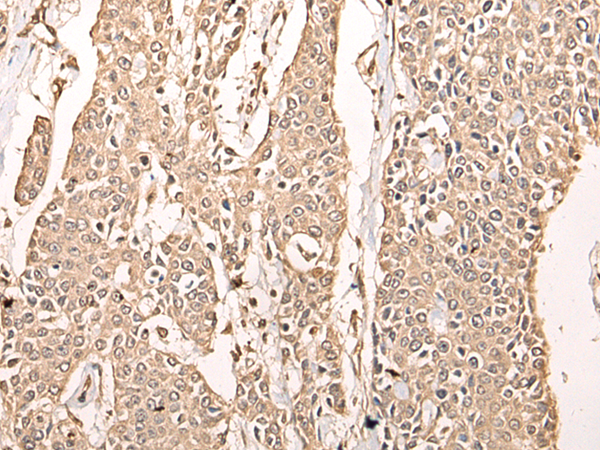
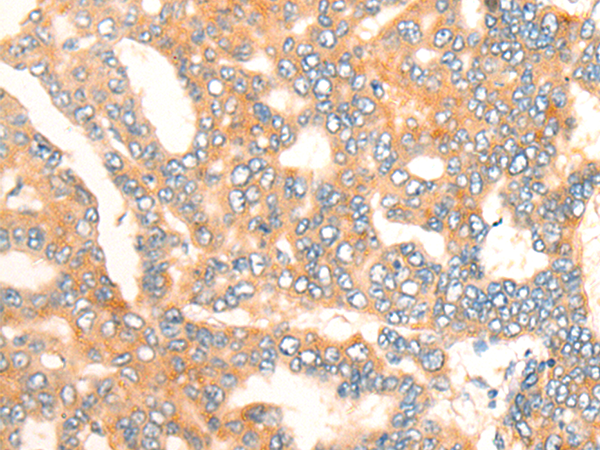
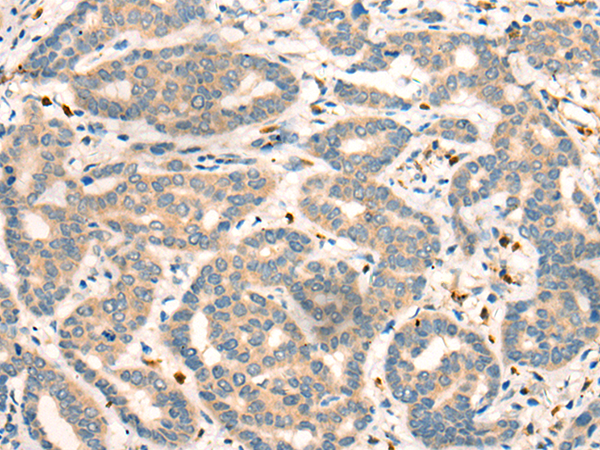

-
分类: 科研抗体货号: P09339别名: AT3; JOS; MJD; ATX3; MJD1; SCA3应用: IHC反应种属: Human
-
分类: 科研抗体货号: P09340别名: ATFA应用: WB,IHC反应种属: Human
-
分类: 科研抗体货号: P09355别名: BAZF; ZNF62; ZBTB28应用: WB,IHC反应种属: Human, Mouse
-
分类: 科研抗体货号: P09338别名:应用: WB,IHC反应种属: Human, Mouse, Rat
-
分类: 科研抗体货号: P09354别名: BDK; BCKDKD应用: IHC反应种属: Human
-
分类: 科研抗体货号: P09364别名: BLU; FLU; CILD22应用: IHC反应种属: Human, Mouse, Rat
-
分类: 科研抗体货号: P09353别名: HBP2; ARTC1; MDS001; HSPC339应用: IHC反应种属: Human
-
分类: 科研抗体货号: P09362别名: BVR; BLVR; BVRA应用: WB,IHC反应种属: Human, Mouse, Rat
-
分类: 科研抗体货号: P09352别名: C12orf58应用: WB,IHC反应种属: Human
-
分类: 科研抗体货号: P09361别名:应用: WB,IHC反应种属: Human, Mouse, Rat

鄂公网安备42018502007531号
鄂公网安备42018502007531号

